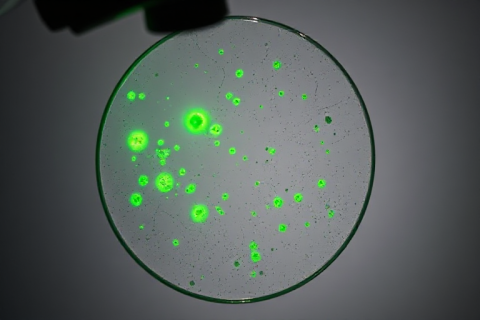

HIGHLIGHTS Researchers pioneer AI-powered predictive health modeling in UK and Denmark. AI forecasts diseases long before symptoms become apparent,...
Archive for month: November, 2025
HIGHLIGHTS The tech industry is poised to invest a staggering amount in artificial intelligence, with estimates suggesting a whopping...
Rethink Human-AI Collaboration Now to Remain Competitive
, AI VALUE POTENTIAL, ENTERPRISE INTEGRATION, REQUIRED CAPABILITIESHIGHLIGHTS Organizations adapt to AI transformations across industries to remain competitive. Employees must rethink roles and responsibilities as AI...
AI Spending Surge Imperils SDGs as $4.2 Trillion Gap Looms
, AI VALUE POTENTIAL, OVERCOMING CHALLENGESHIGHLIGHTS The world’s financial wealth surged to a staggering $305 trillion in 2024, yet the funding shortfall for achieving...
HIGHLIGHTS Graduates of the Future Pathway program are leaving their mark on Salesforce. Selene Tenorio has dedicated herself to...
AI-Powered Breakthrough: DeepEGFR Identifies Novel Cancer Therapeutics
, AI VALUE POTENTIAL, REQUIRED CAPABILITIESHIGHLIGHTS Researchers develop innovative approach to identify cancer therapeutics targeting Epidermal Growth Factor Receptor (EGFR). DeepEGFR categorizes small compounds...
Revolutionizing Industries: AI Breakthroughs Transform Global Economy
, AI VALUE POTENTIAL, COMPANY/PRODUCT NEWSHIGHLIGHTS Ralph Lauren introduces AI-driven personalized fashion experience with “Ask Ralph” solution. Priva harnesses AI to optimize plant care,...
80% of Engineers Bypass Security with Unauthorized Tools IT professionals and security experts frequently experience conflicts over technology adoption,...
Alphabet Unveils Pomelli: AI-Powered Social Media Game-Changer
, AI VALUE POTENTIAL, COMPANY/PRODUCT NEWSHIGHLIGHTS Alphabet introduces Pomelli, a groundbreaking social media content engine designed specifically for small and midsize businesses. Pomelli’s innovative...
NVIDIA Powers South Korea’s National AI Initiative with 50,000 GPUs
, AI VALUE POTENTIAL, COMPANY/PRODUCT NEWSHIGHLIGHTS South Korea unveils ambitious national AI project with leading organizations. NVIDIA’s CEO Jensen Huang spearheads massive rollout of...
Recent Posts
- 2025-11-26: AI Dominates 2025: Breakthroughs, Adoptions, and Innovations Soar
- Google Unveils 7th-Gen Ironwood TPU, 4x Performance Boost for AI
- Amazon Web Services (AWS) Unveils Breakthrough Bidirectional Streaming for Real-Time AI Dialogue in 2025
- Google’s Gemini 3 AI Model Surpasses Competitors, Stock Soars 12%
- Salesforce Unveils 2-Year Plan for Secure AI Commerce Breakthrough